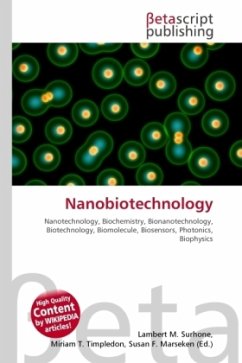
Cover Nanobiotechnology

Prospects in Nanobiotechnology
Research into bioproducts from the Brazilian Amazon
Versandkostenfrei!
Versandfertig in 6-10 Tagen
24,99 €
inkl. MwSt.

PAYBACK Punkte
12 °P sammeln!
When we think about the biodiversity of fauna and flora, the Brazilian Amazon forest stands out among the humid tropical forests for its great genetic diversity, and is the subject of numerous studies and research. In this sense, the cupuaçu tree Theobroma grandiflorum (SHUM.), a typical tree of the Amazon region, appears to be the second most important economic species of the Theobroma genus, after cocoa, and its fat has received attention for presenting edible properties similar to chocolate and moisturizing and emollient characteristics with application in the cosmetics industry. This spec...
When we think about the biodiversity of fauna and flora, the Brazilian Amazon forest stands out among the humid tropical forests for its great genetic diversity, and is the subject of numerous studies and research. In this sense, the cupuaçu tree Theobroma grandiflorum (SHUM.), a typical tree of the Amazon region, appears to be the second most important economic species of the Theobroma genus, after cocoa, and its fat has received attention for presenting edible properties similar to chocolate and moisturizing and emollient characteristics with application in the cosmetics industry. This species is widespread throughout the Amazon basin and is easily found; research aimed at enhancing the value of these products could help strengthen their production chain, contributing to the conservation and sustainable development of the activities carried out by the people who live in this region. Research into nanotechnology is still new for products from the Brazilian Amazon and could lead to the discovery of new products.